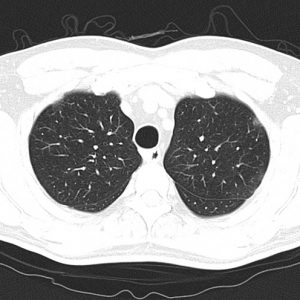
Viêm phổi Covid-19

HÔ HẤP
Hiển thị 101–120 của 450 kết quảĐã sắp xếp theo mới nhất
-

Tràn dịch màng phổi
Lượt xem: 135» 16-05-2020 -

Siêu âm viêm phổi
Lượt xem: 142» 15-05-2020 -

Nang phế quản
Lượt xem: 238» 13-05-2020 -

Apxe phổi
Lượt xem: 339» 08-05-2020 -

Viêm phổi Covid-19
Lượt xem: 86» 04-05-2020 -

Ung thư phổi
Lượt xem: 530» 02-05-2020 -

U màng phổi
Lượt xem: 271» 01-05-2020 -

U màng phổi
Lượt xem: 255» 01-05-2020 -

Viêm mủ màng phổi
Lượt xem: 164» 28-04-2020 -

Viêm phổi Covid-19
Lượt xem: 845» 27-04-2020 -

U trung thất
Lượt xem: 610» 25-04-2020 -

U trung thất sau
Lượt xem: 243» 23-04-2020 -

Khí phế thũng
Lượt xem: 2564» 22-04-2020 -

U phổi
Lượt xem: 184» 16-04-2020 -

Thoát vị hoành
Lượt xem: 203» 14-04-2020 -

Viêm phổi
Lượt xem: 368» 06-04-2020 -

Tràn khí màng phổi
Lượt xem: 682» 02-04-2020 -

Lao phổi
Lượt xem: 323» 31-03-2020 -

Viêm phổi Covid-19
Lượt xem: 214» 26-03-2020 -

Viêm phổi Covid-19
Lượt xem: 175» 26-03-2020